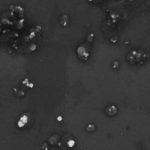

En el marco de la pandemia de coronavirus (Covid-19) y la aceleración del plan de vacunación en Argentina, surge la inquietud sobre si se puede consumir alcohol antes o después de recibir la vacuna contra el virus.
El director del Centro Nacional ruso de Investigación de Epidemiología y Microbiología de Gamaleya y desarrollador de la vacuna rusa Sputnik V, Alexánder Gíntsburg, informó a fines del año pasado por cuánto tiempo una persona debe abstenerse de consumir bebidas alcohólicas.
El experto recomendó «encarecidamente» no consumir alcohol durante tres días de aplicada la inyección. «Por supuesto, no estamos hablando de una prohibición total del alcohol durante la vacunación. Solo se trata de una restricción razonable del consumo hasta que el cuerpo haya formado su propia respuesta inmune a la infección por coronavirus», aclaró.
Además, destacó que la recomendación no refiere únicamente a dosis de Sputnik V, sino a «cualquier otra vacuna». En este sentido, tampoco debería ingerirse alcohol si se recibe otra de las vacunas disponibles en Argentina, como la Covishield de AstraZeneca o Sinopharm del Instituto de Biotecnología de Beijing.
En tanto, Sergiu Padure, profesor de inmunología en la Universidad CEU San Pablo, de Madrid, explicó que en cantidades pequeñas y en personas que no beben de manera crónica, no debería existir una interferencia con la inmunización. Esto se debe a que “el alcohol se metaboliza a través del hígado y la respuesta inmunológica de la vacuna suele ocurrir en los órganos linfoides periféricos. Se trata de una cuestión de metabolismo”, dijo el especialista a Cuidate Plus.
Sin embargo, a pesar de que no exista una aparente repulsión o efectos secundarios por el consumo de alcohol antes o despues de la vacunación, se recomienda no consumirlo al menos dentro de 48 horas.
«De hecho, muchos pacientes tienen reacciones adversas, que pueden ir desde las molestias locales en el lugar de la inyección a malestar, fiebre, febrícula… Tiene mucho más sentido no fomentar el consumo de alcohol para no potenciar esas reacciones”, señala Lorenzo Armenteros, portavoz Covid-19 de la Sociedad Española de Médicos Generales y de Familia.
De esta manera, los especialistas recomiendan no realizar un consumo excesivo de bebidas alcohólicas antes de recibir cualquier vacuna en general, ya que las evidencias científicas indican que su abuso puede perjudicar el funcionamiento de nuestro sistema de defensas.
Fuente: baenegocios.com